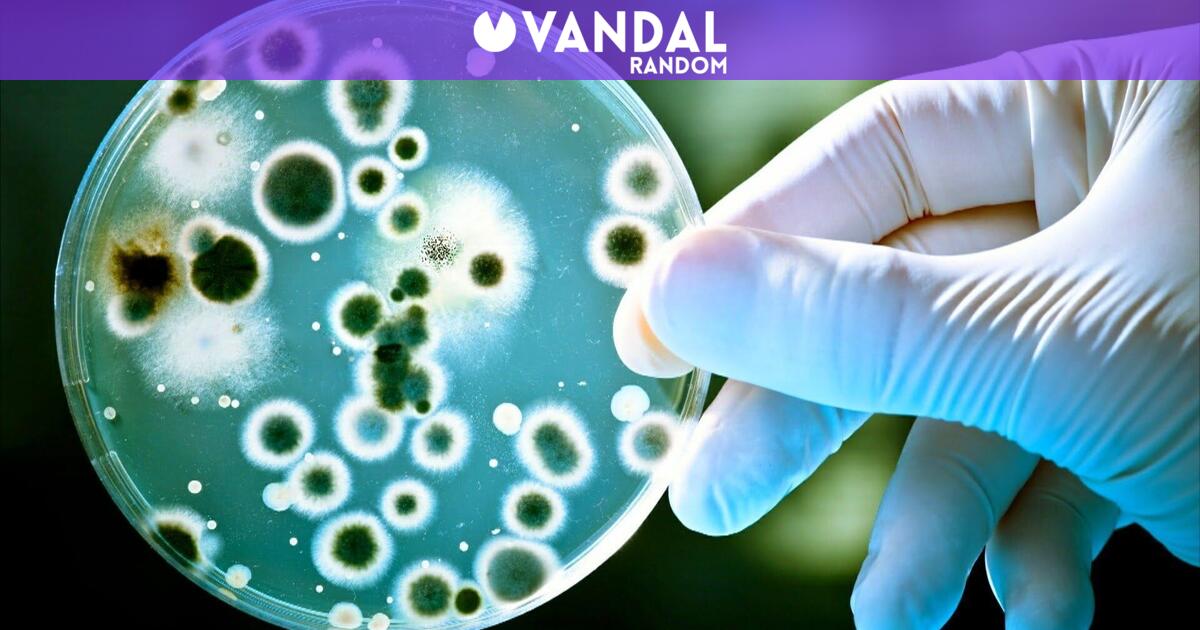
Image

La idea de las bacterias ‘espejo’ ha captado la atención de la comunidad científica desde su propuesta inicial en 2019, prometiendo revolucionar el entendimiento sobre la biología y la farmacología. Ahora, sin embargo, la misma ciencia que despertó esperanzas se enfrenta a un abrumador escepticismo. Investigadores que una vez vieron en estos microbios una oportunidad única han comenzado a alertar sobre los peligros que podrían conllevar la creación de organismos que, aunque similares a los naturales, podrían resultar mortales. Este temor radica en la posibilidad de que las bacterias espejo, al interactuar con sus homólogas naturales, podrían alterar ecosistemas enteros, provocando un escenario apocalíptico para la vida en la Tierra, un llamado de atención que resuena en los foros científicos y académicos alrededor del mundo.
A medida que los trabajadores tecnológicos en China enfrentan el avance de la automatización y la inteligencia artificial, un nuevo proyecto en GitHub ha reavivado la conversación sobre el futuro de la identidad profesional en un entorno cada vez más dominado por las máquinas. Con Colleague Skill, la idea de replicar habilidades y personalidades ha levantado un auténtico revuelo entre los empleados, muchos de los cuales sienten que sus jefes están presionando para documentar cada aspecto de su trabajo con el objetivo de ser reemplazados por agentes automáticos. Esta sensación de pérdida de control y de identidad está llevando a algunos a explorar maneras de sabotear las herramientas de automatización que amenazan su lugar en la economía laboral.
El diálogo entre la Casa Blanca y Anthropic, en un momento de tensión por la regulación de la tecnología, también responde a la necesidad de encontrar un compromiso que permita equilibrar la innovación con la seguridad. Tras una reunión calificada de ‘productiva’, a pesar de un ambiente de hostilidad –incluyendo la orden para que las agencias del gobierno se deshicieran de las tecnologías de Anthropic–, surgen importantes interrogantes sobre cómo será el futuro de la inteligencia artificial en el contexto político norteamericano. Mientras tanto, la NSA ya está aprovechando las capacidades de los nuevos modelos de IA de la compañía, lo que pone de manifiesto la complejidad de la relación entre las políticas gubernamentales y los avances privados en tecnología.
La propuesta de un servicio nacional universal por parte de Palantir, descrita en un manifiesto reciente, pone en evidencia la creciente desesperación dentro de la industria tecnológica por encontrar un camino hacia adelante en medio de culturas laborales que son vistas como desfavorables. El CEO Alex Karp sostiene que su visión puede ayudar a afrontar los desafíos actuales, mientras que críticos argumentan que la metodología de Palantir podría ser más una estrategia de marketing corporativo que una solución honesta a problemas complejos de la sociedad. Esta tensión entre lo que se dice y lo que verdaderamente se necesita dentro de la comunidad tecnológica agrega otra capa a la conversación sobre el futuro de la IA y su impacto en la vida cotidiana.
Finalmente, la crisis global de residuos electrónicos tiene un nuevo aliado en la forma de la inteligencia artificial, que promete agravar un problema ya de por sí alarmante. La mayoría de la manga de basura electrónica acaba en países menos desarrollados, donde las infraestructuras para manejar desechos son insuficientes. La producción acelerada de tecnología alimentada por la IA contribuye a este ciclo vicioso de consumo y desecho, agravando el problema del reciclaje y la sostenibilidad. Con la colaboración de gobiernos y empresas, será fundamental implementar estrategias efectivas de reciclaje y restauración para mitigar el daño ambiental que se avecina.